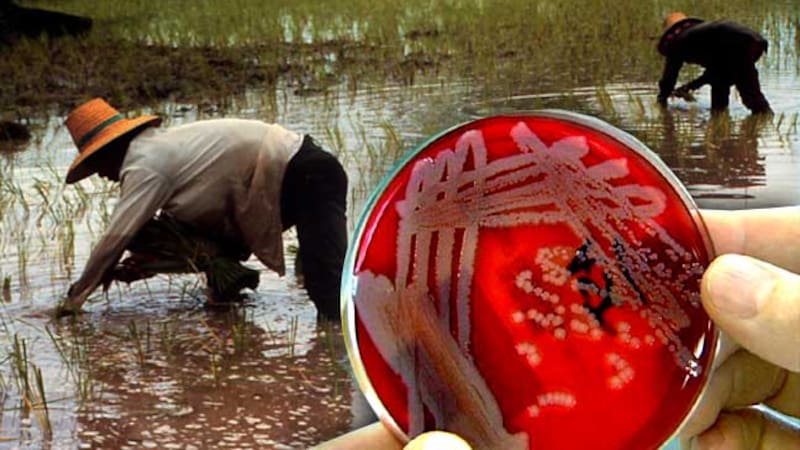
<div class="migrated-promo-image__description"><div class="migrated-promo-image__source">Fuente: Archivo</div></div>

Recientemente, la Secretaría de Salud alertó a la población por un reciente brote de una enfermedad infecciosa que puede ser mortal. Oficialmente, ya se confirmaron confirmación de cinco casos de melioidosis, una enfermedad infecciosa causada por la bacteria Burkholderia pseudomallei.
La Secretaría de Salud de Baja California Sur ya emitió información oficial sobre la enfermedad y sus peligros. El último antecedente se remonta a la primera semana de noviembre de 2023, cuando se confirmaron cinco casos de melioidosis a través del Sistema de Vigilancia Epidemiológica de Enfermedades por Bacterias Invasivas.
Qué es la melioidosis, la nueva enfermedad mortal
La melioidosis es una enfermedadinfecciosa causada por la bacteria Burkholderia pseudomallei. El microorganismo que causa la enfermedad se encuentra en suelos y aguas estancadas de regiones tropicales y subtropicales. La enfermedad puede afectar a personas y animales que entran en contacto directo con estos ambientes contaminados.
Una de las características más peligrosas de la enfermedad melioidosis es que puede estar latente en el cuerpo sin presentar ningún síntoma durante años, hasta que pueden "despertarse" y convertirse en una enfermedad grave. La melioidosis afecta particularmente a personas con ciertos factores de riesgo como enfermedadescrónicas, supresión del sistema inmunológico o consumo habitual de alcohol.

¿Cómo se transmite la melioidiosis?
La enfermedad tiene varias vías de transmisión, siendo la más común la de ingesta de alimentos contaminados.
- Inhalación: Es la forma más común de contagio, al inhalar polvo contaminado con la bacteria.
- Contacto con agua o tierra contaminada: La bacteria puede entrar al cuerpo a través de heridas abiertas o abrasiones en la piel.
- Ingestión de agua o alimentos contaminados: La bacteria puede contaminar agua y alimentos, especialmente en zonas rurales.
Cuáles son los síntomas de la melioidiosis
Los síntomas de la melioidiosis pueden variar ampliamente, desde leves hasta graves, e incluso pueden ser similares a los de otras enfermedades, lo que dificulta el diagnóstico. Algunos síntomas comunes son:
- Fiebre
- Dolor de cabeza
- Dolor muscular
- Dificultad para respirar
- Tos
- Neumonía
- Dolor abdominal
- Diarrea
En México, la melioidiosis es una enfermedad endémica en algunos estados, como Chiapas, Tabasco y Campeche. Ya en 2023, se había detectado un aumento en el número de casos en el estado de Veracruz.
Estas son algunas de las recomendaciones que puedes tener en cuenta para protegerte de la enfermedad.
- Si reside en una zona de riesgo o ha viajado a una, consulte a un médico si presenta síntomas de melioidiosis.
- Es importante informar a los médicos sobre sus viajes y actividades para un diagnóstico preciso.
- Las autoridades sanitarias están trabajando para controlar la enfermedad y prevenir su propagación.













